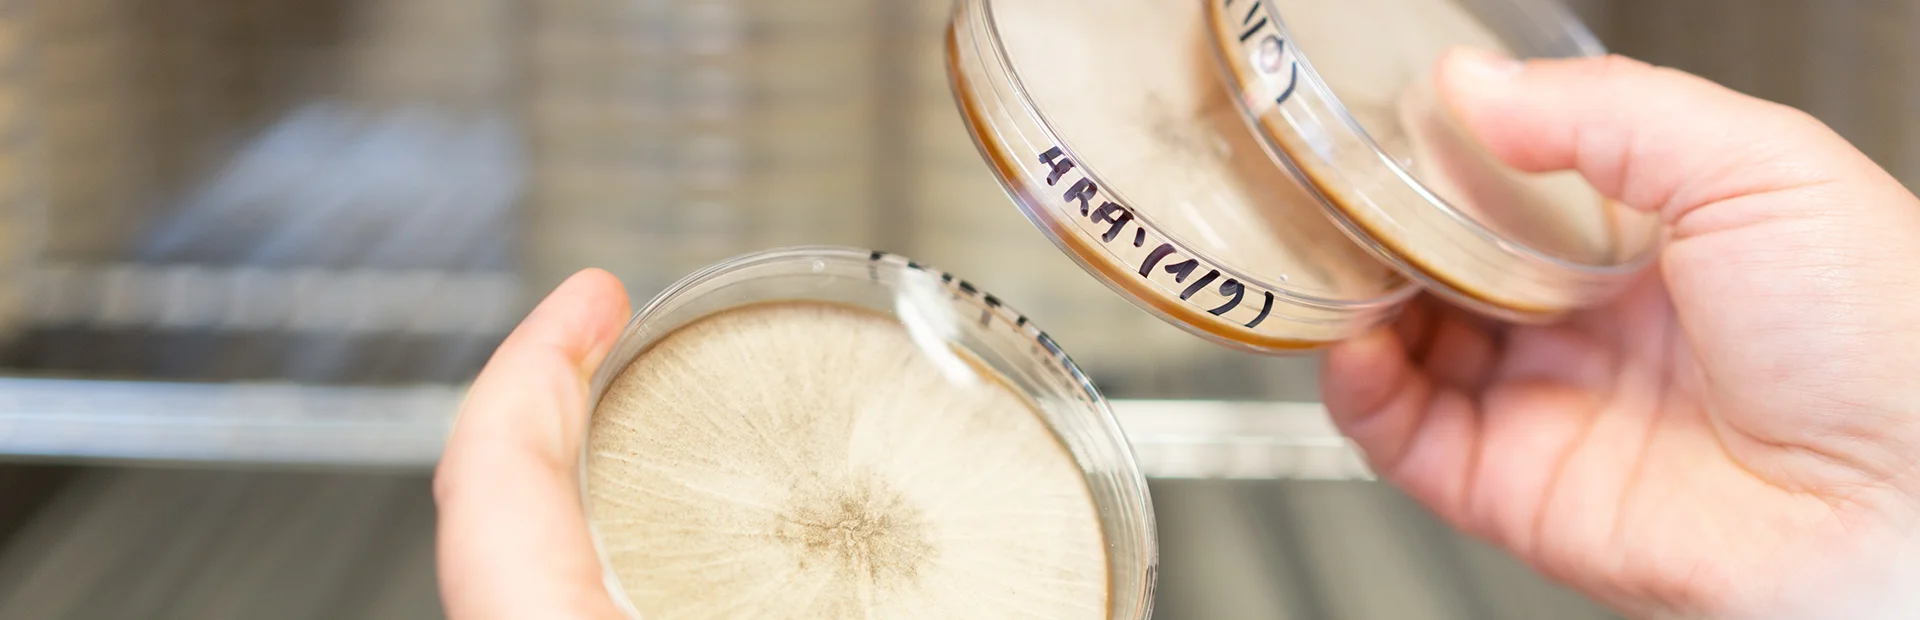

Vous travaillez dans l’industrie alimentaire ou des boissons et vous recherchez des solutions durables pour améliorer vos produits ? Découvrez nos enzymes non OGM, également disponibles sans conservateurs.
Vous envisagez d’autres applications ou processus innovants ?
Découvrez notre solution d’outils enzymatiques qui répond à vos besoins !
DÉCOUVREZ SOLYVE
Découvrez les avantages des enzymes
OGM
À propos

Proximité avec le client
Notre équipe d’experts, de scientifiques et de techniciens est là pour vous accompagner dans la réalisation de vos objectifs. Nous offrons des solutions personnalisées et une expertise dans un large éventail d’applications alimentaires et plus encore.

Expertise en formulation
Depuis 35 ans, nous développons des méthodes et des bases de données qui nous permettent aujourd’hui de recommander rapidement la meilleure combinaison enzymatique pour vos besoins, afin d’améliorer vos procédés.

Qualité de service et fiabilité de nos produits
La sécurité alimentaire, le contrôle de processus et votre satisfaction sont au cœur de nos préoccupations quotidiennes.